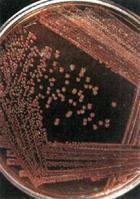
傷寒桿菌

中醫學定義
廣義傷寒是一切外感熱病的總稱。狹義傷寒是外感風寒之邪,感而即發的疾病。《素問·熱論》說:“今夫熱病者,皆傷寒之類也。”指的是廣義傷寒。
 傷寒桿菌
傷寒桿菌《難經·五十八難》:“傷寒有五,有中風,有傷寒,有濕溫,有熱
病,有溫病。”其“傷寒有五”之傷寒為廣義傷寒,五種之中的傷寒為狹義傷寒。
有關傷寒的記載,始見於《內經·素問》。繼後,《難經》明確指出,傷寒的涵義有廣有狹,廣義傷寒包括狹義傷寒以及中風(感受風邪所致的外感病,不同於雜病中風)、溫病、熱病、濕溫等疾病,即以傷寒名稱兼賅風、濕、熱等病邪所致的多種外感疾病。漢代張仲景“勤求古訓,博採眾方”,以六經證治為綱要,撰寫了《傷寒論》一書,使中醫學理法方藥得到和諧統一,從而奠定了辨證論治的基礎,無論對外感熱病和其他系統疾病,都有重要的指導意義。傷寒的致病因素包括外因、內因。廣義傷寒各種疾病的外因為風、寒、暑、濕、燥、火六淫之邪;狹義傷寒由冬令感受風寒所致。傷寒發病的內因為正氣虛虧,如果素體虛弱,或勞倦飢餓,起居失常,寒溫不適,房事不節,均可導致正氣虛虧,易被外邪侵犯成病。
病理病因
傷寒桿菌
傷寒桿菌傷寒桿菌屬沙門氏菌屬,革蘭染色陰性,呈短粗桿狀,體周滿布鞭毛,運動活潑,在含有膽汁的培養基中生長較好,因膽汁中的類脂及色氨酸可作為傷寒桿菌的營養成分。傷寒桿菌的菌體(O)抗原、鞭毛(H)抗原和表面(Vi)抗原能使人體產生相應的抗體。由於O及H抗原的抗原性較強,故可用於血清凝集試驗(肥達反應,Widal reaction),以測定血清中的O及H抗體的效價來輔助臨床診斷。菌體裂解時可釋放強烈的內毒素,是傷寒桿菌致病的主要因素。利用沙門菌的invA基因和鞭毛素基因用PCR方法擴增進行分子雜交,可以檢出3~300活菌細胞,達到敏感和特異的效果。
傳染源
傷寒和帶菌者是本病的傳染源。病菌隨糞便和尿排出體外,通過污染飲水和食物,經口感染。蒼蠅在本病的傳播上起媒介作用。
病理病變
傷寒是主要累及全身單核吞噬細胞系統的感染性疾病,病變突出表現在腸道淋巴組織,腸系膜淋巴結、肝、脾和骨髓等處。此外,由於敗血症的存在,在病菌及其釋放的內毒素作用下,全身許多器官也可受累。
傷寒桿菌引起的炎症屬急性增生性炎症,主要是巨噬細胞的增生。其吞噬能力十分活躍,胞漿中常吞噬有傷寒桿菌、受損的淋巴細胞、紅細胞及壞死細胞碎屑,在病理診斷上具有一定的意義,故常稱這種細胞為傷寒細胞。傷寒細胞常聚集成團,形成小結節,稱為傷寒肉芽腫或傷寒小結(圖18-19)。革蘭染色可見傷寒細胞胞漿內含有被吞噬的傷寒桿菌。傷寒桿菌引起的炎性反應的特點是病灶內無中性粒細胞滲出。
腸道病變
以迴腸下段的集合和孤立淋巴小結的病變最為常見和明顯。按病變自然發展過程可以下四期,每期約1周。
(1)髓樣腫脹期:在起病的第一周,迴腸下段淋巴組織明顯腫脹,凸出於黏膜表面,色灰紅,質軟。其中以集合淋巴小結腫脹最為突出,表面形似腦回樣隆起(圖18-20)。腸黏膜有充血、水腫、粘液分泌增多等變化。
(2)壞死期:從發病的第二周開始進入壞死期,腫脹的淋巴組織在中心部發生多數灶性壞死,並逐步融合擴大,累及黏膜表層。壞死組織失去正常光澤,色灰白或被膽汁染成黃綠色。
(3)潰瘍期:一般發生於發病後第三周。由於壞死組織逐漸崩解脫落、形成潰瘍。潰瘍邊緣稍隆起,底部高低不平。(圖18-21)潰瘍一般深及黏膜下層,壞死嚴重者可深達肌層及漿膜層,甚至穿孔,如侵及小動脈,可引起嚴重出血。
(4)癒合期:相當於發病後的第四周。潰瘍面壞死組織已完全脫落乾淨,並長出肉芽組織將潰瘍填平,然後由潰瘍邊緣的上皮再生復蓋而告癒合。
由於上述腸道病變,臨床上每有食慾減退、腹部不適、腹脹、便秘或腹瀉及右下腹輕壓痛。糞便細菌培養在病程第二周起陽性率逐漸增高,在第3~5周陽性率最高可達85%。
由於臨床早期套用有效抗生素如氯黴素,以上四期的病變極不典型。
其他單核吞噬細胞系統的病變
 傷寒桿菌
傷寒桿菌(1)腸系膜淋巴結:迴腸下段附近的腸系膜淋巴結常顯著腫大,充滿大量吞噬活躍的巨噬細胞,也可有傷寒肉芽腫和灶性壞死形成。
(2)脾:中度腫大,約為正常的2~3倍,包膜緊張。切面呈混濁的暗紅色,質甚軟,有時如果醬樣,並可用刀背刮下,脾小體不清楚。鏡下見巨噬細胞瀰漫性增生,並可有傷寒肉芽腫和灶性壞死形成。臨床上在發病後第六天左右可觸及腫大的脾,質軟並具壓痛。
(3)肝:肝腫大,質軟。肝細胞呈高度濁腫,並有散在、邊界較清的傷寒肉芽腫形成,肝竇擴張充血,匯管區可見單核細胞和淋巴細胞浸潤。肝細胞也可因細菌毒素的直接作用或傷寒小結壓迫引起的缺血而發生灶性壞死。
(4)骨髓:也有巨噬細胞增生、傷寒肉芽腫和灶狀壞死形成。由於骨髓中的巨噬細胞攝取病菌較多,存在時間較長,故骨髓培養陽性率可高達90%,較血培養為高。
其他臟器的病變
(1)膽囊:雖然傷寒桿菌易在膽汁中大量繁殖,但數患者膽囊無明顯病變或僅有輕度炎症。值得注意的是,病人臨床痊癒後,細菌仍可在膽汁中生存,並通過膽汁由腸道排出,在一定時期內仍是帶菌者,有的患者甚至可成為慢性帶菌者或終身帶菌者。
(2)心肌:心肌纖維有較重的混濁腫脹。重症患者可出現中毒性心肌炎。毒素對心肌的影響或毒素導致的迷走神經興奮性增高,或許是臨床上出現特徵性重脈或相對緩脈的原因。
(3)腎:腎曲管上皮可發生混濁腫脹,以往認為臨床上出現的蛋白尿與此有關。但近年來通過腎活檢免疫螢光檢查,發現腎小球毛細血管壁可有免疫球蛋白(IgG,IgM)及補體(C3)沉著,並查見Vi抗原,因此考慮為免疫複合物性腎炎,但這種腎的病變可迅速消退。尿培養早期多為陰性,病程第3~4周的陽性率約為25%。
(4)皮膚:部分患者在病程第7~13天,皮膚出現淡紅色小斑丘疹,稱玫瑰疹,以胸、腹及背部為多,一般在2~4天內消失。在皮疹中可查見傷寒桿菌。
(5)肌肉:膈肌、腹直肌和股內收肌常發生凝固性壞死(亦稱蠟樣變性)。臨床出現肌痛和皮膚知覺過敏。
併發症況
1.腸出血和腸穿孔均多發生於潰瘍期。腸出血嚴重者可引起出血性休克。腸穿孔是傷寒最嚴重的併發症,穿孔多為一個,有時也可多個,且發生在腸脹氣和腹瀉的情況下,穿孔後常引起瀰漫性腹膜炎。這兩種併發症的發生率約為1%~5%。
2.支氣管肺炎以小兒患者並發為多,常因抵抗力下降,繼發肺炎球菌或其他呼吸道細菌感染所致,極少數病例也可由傷寒桿菌直接引起。
3.其他傷寒桿菌可借血道感染其他器官,如骨髓、腦膜、腎(腎實質及腎盂),關節,但皆少見。膽囊的感染常見且重要,因膽囊炎若成慢性,將長期排出傷寒菌作為本病的傳染源。
在無併發症的情況下,一般經過4~5周就可痊癒,病後可獲得較強的免疫力。敗血症、腸出血和腸穿孔是本病重要的死亡原因。自從使用抗生素治療傷寒以來,病程顯著縮短,臨床症狀也大為減輕,典型的傷寒腸道各期的病變及全身病變已屬少見,但復發率卻有一定的增加。
治療方法
治療傷寒應掌握辨證論治原則。傷寒六經病總的治則為祛除外邪,扶助正氣。三陽病多屬表證、熱證、實證,以祛邪為主,三陰病多屬里虛寒證,治法應以扶正為主。但傷寒病的診治較為複雜,倘若誤治,可致變證迭現。如太陽病雖有表邪,但不能發汗太過,否則津液耗傷,甚則汗多亡陽;太陽病表邪未解,不可誤行攻下,否則可成痞證或結胸;少陽病邪在半表半里,故汗、吐、下法皆在所禁;陽明病腸胃燥熱,故禁發汗及利小便,以免重傷津液;陽明邪熱在經,尚未與燥屎相合,不可過早攻下;少陰病陰陽皆虛,不可誤汗、誤下等等。
相關知識
簡介
副傷寒(paratyphoidfever)是由副傷寒桿菌所致的急性傳染病。副傷寒的臨床表現與傷寒相似,但一般病情較輕,病程較短,病死率較低。副傷寒丙尚可表現為急性胃腸炎或膿毒血症。
病原學
副傷寒的病原體有3種,副傷寒甲桿菌、副傷寒乙桿菌及副傷寒丙桿菌。各種副傷寒桿菌均有“O”和“H”抗原,在自然條件下,副傷寒桿菌一般只能感染人類,僅偶而感染動物。
流行病學
 傷寒桿菌
傷寒桿菌傳染源為病人和帶菌者。傳播方式與傷寒大致相同,但以食物傳播較為常見,因副傷寒桿菌可在食物中較長時間存在。
我國副傷寒的發病率較傷寒為低。成年人中以副傷寒甲為多,兒童易患副傷寒乙,但可因地區、年代等而不同。
發病原理與病理變化
副傷寒甲、乙的發病機理與病理變化大致與傷寒相同,副傷寒丙的腸道病變較輕,腸壁可無潰瘍形成,但體內其它臟器常有局限性化膿病變,可見於關節、軟骨、胸膜、心包等處。
臨床表現
副傷寒的潛伏期較傷寒短,一般為8~10天,有時可短至3~6天。副傷寒甲、乙的症狀與傷寒類似,但副傷寒丙的症狀較特殊。
(一)副傷寒甲、乙起病徐緩,但驟起者不少見,尤以副傷寒乙為多。開始時可先有急性胃腸炎症狀如腹痛、嘔吐、腹瀉等,約2~3天后症狀減輕,繼而體溫升高,傷寒樣症狀出現。發熱常於3~4天內達高峰,波動較大,極少稽留。熱程較傷寒短,毒血症狀較輕,但腸道症狀則較顯著。皮疹出現較早,且數量多,直徑大。復發與再燃多見,而腸出血、腸穿孔少見。
(二)副傷寒丙臨床症狀複雜,常見有以下三種類型:
1.傷寒型症狀與副傷寒甲、乙大致相似,但較易出現肝功異常。
2.胃腸炎型以胃腸炎症狀為主,表現為發熱、噁心、嘔吐、腹痛、腹瀉,病程短。
3.膿毒血症型常見於體弱兒童和慢性消耗疾病患者。發病急、寒戰、高熱、熱型不規型,熱程1~3周不等。常有皮疹、肝脾腫大、並可出現黃疸。半數以上病人可出現胸膜炎、膿胸、關節及骨的局限性膿腫、腦膜炎、心包炎、心內膜炎、腎盂炎等遷徙性化膿性併發症,此類併發症極頑固,治療期長且困難。
副傷寒甲、乙、丙的診斷、治療及預防等與傷寒大致相同。對並發化膿性病灶者,一旦膿腫形成,可行外科手術治療,並加強抗菌藥物的使用。
存活
 傷寒桿菌
傷寒桿菌在自然環境中抵抗力強,耐低溫,水中可存活2~3周,在糞便中可維持1~2個月,冰凍環境可維持數月,但對熱和乾燥的抵抗力較弱,60℃15分鐘或煮沸後即可殺滅,對一般化學消毒劑敏感,消毒飲水余氯0.2~0.4mg/L時迅速死亡。
抗原
 傷寒桿菌
傷寒桿菌傷寒桿菌有三種抗原,稱為O抗原、Vi抗原及H抗原。
O抗原:體抗原D群;
Vi抗原:莢膜抗原
H抗原:鞭毛抗原。
引發疾病
傷寒桿菌(Salmonellatyphi)造成之傷寒病,常稱“傷寒熱”(typhoidfever),其症狀包括高燒,可達39°至40°C(103°至104°F);其他症狀有腹痛、嚴重腹瀉、頭痛、身體出現玫瑰色斑(rosespot)等。腸道出血或穿孔是其最嚴重的併發症。其傳染途徑為糞口途徑,傳染力很高。菌體裂解時可釋放強烈的內毒素,是傷寒桿菌致病的主要因素。
發病機制
傷寒桿菌隨污染的飲水或食物進入消化道後,穿過小腸黏膜上皮細胞侵入腸壁的淋巴組織,特別是迴腸下段的集合淋巴小結和孤立淋巴小結,並沿淋巴管至腸系膜淋巴結。在些淋巴組織內,傷寒桿菌一方面被巨噬細胞吞噬,並在其中生長繁殖;另一方面經胸導管進入血液,引起菌血症。血液中的病菌很快被全身單核吞噬細胞系統如肝、脾,骨髓和淋巴結中的巨噬細胞吞噬,並進一步在其中大量繁殖。在這一段時間內,雖然有單核吞噬細胞系統的增生反應,但臨床上無明顯症狀,稱為潛伏期,一般10天左右。
此後,在全身單核吞噬細胞系統內繁殖的病菌及其釋放的內毒素再次大量進入血液,並隨之散布至全身各臟器和皮膚等處,引起敗血症和毒血症,呈現全身中毒性症狀和病理改變。病變主要發生於迴腸末段,其腸壁的淋巴組織出現明顯的增生腫脹,此時相當於疾病的第一周,血培養常為陽性。隨著病程的發展,在發病後的第2~3周,傷寒桿菌在膽囊內繁殖到一定數量,大量病菌隨膽汁再度進入小腸,又可穿過腸黏膜再次侵入腸道淋巴組織,使原已致敏的腸壁淋巴組織發生強烈的過敏反應,導致壞死、脫落和潰瘍形成。傷寒桿菌隨同脫落的壞死組織和糞便排出體外,故此段時間糞便培養易獲陽性結果。與此同時,人體的免疫力逐漸增加,血中的抗體不斷上升,肥達反應在病程第二周以後多數出現陽性。但近年來有研究證明血中抗體滴度的高低與患者對傷寨桿菌的抵抗力無關,而系細胞免疫在對抗病菌上起主要作用。即在致敏T細胞所產生的某些淋巴因子的作用下,增強巨噬細胞的吞噬、滅菌功能。在病程的第四周,隨著免疫力的增強,血液和器官內的細菌逐漸消失,中毒症狀減輕、消失,病變隨之癒合而告痊癒。
預防
1.患病時首先要隔離,注意休息,嚴格臥床,排泄物應徹底消毒。
2.注意觀察體溫、脈搏、血壓、腹部情況及大便性狀的變化。注意保持患者的口腔和皮膚衛生。
3.高熱時可用冰敷、酒精等物理降溫方式,不套用大量退熱藥,以免虛脫。
4.患者在體溫正常的15天后,或5天做糞便培養一次,連續兩次陰性,可以解除隔離。
5.患者的大小便、便器、食具、衣物、生活用品都需要消毒處理。帶菌者應調離飲食服務工作崗位。
6.養成飯前便後洗手,不吃不潔食物,不飲用生水、生奶的習慣。
治療
病原治療:選用適當抗菌素。
(1)對非耐藥菌株感染、血象、肝、腎功能正常者,可選用:氯黴素,複方新諾明、丁胺卡那黴素、氨苄青黴素、氟啶酸和其他輔助藥物。
(2)對耐藥菌株感染、血象、肝、腎功能正常者,可選用:氨苄青黴素、丁胺卡那黴素、氟啶酸或氟秦酸、頭孢三秦、頭孢他定和其他輔助藥物。
(3)對妊娠合併傷寒,小兒傷寒,血象低,肝、腎功能不良者,可選用:氨辯青黴素、頭孢三秦、頭孢他定和其他輔助藥物。
(4)對傷寒並發腸出血或腸穿孔者,應聯用抗生素,加強對症支援等綜合治療。
(5)對慢性帶菌者:應選用有效抗菌藥聯用,藥量足、療程長,有並存症者套用特需藥物進行治療。

